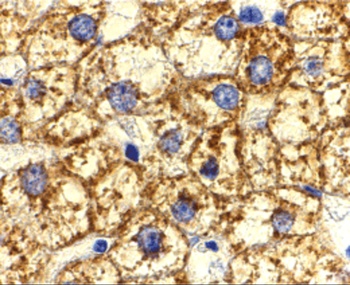
Akt1 Antibody

You have no items in your shopping cart.
Search results for: 'AKT1'
- Phospho-AKT1S1 (T246) Antibody [orb633015]Featured

ELISA, IHC, WB
Human, Mouse, Rat
Rabbit
Polyclonal
Unconjugated
100 μg, 50 μg - AKT1 (Ab-450) Antibody [orb14708]
IF, IHC, WB
Human, Mouse, Rat
Rabbit
Polyclonal
Unconjugated
50 μl, 100 μl IF, IHC, WB
Human, Mouse, Rat
Rabbit
Polyclonal
Unconjugated
50 μl, 100 μl- AKT1 (phospho-Thr450) Antibody [orb14995]
IF, IHC, WB
Human, Mouse, Rat
Rabbit
Polyclonal
Unconjugated
50 μl, 100 μl - AKT1S1 Antibody [orb1240257]Featured

ELISA, IF, IHC-P, WB
Human, Mouse, Rat
Polyclonal
Unconjugated
0.1 mg, 0.02 mg - Akt1 Antibody [orb1240258]
ELISA, IF, IHC-P, IP, WB
Human, Mouse, Rat
Bovine
Polyclonal
Unconjugated
0.1 mg, 0.02 mg - AKT Rabbit pAb [orb1565603]Featured

FC, ICC, IF, IHC-P, IP, WB
Human, Mouse, Rat
Polyclonal
Unconjugated
100 μl, 50 μl, 20 μl - AKT Rabbit mAb [orb1563078]Featured

ICC, IF, IHC-Fr, IHC-P, IP, WB
Hamster, Human, Mouse, Rat
Monoclonal
Unconjugated
100 μl, 50 μl, 20 μl